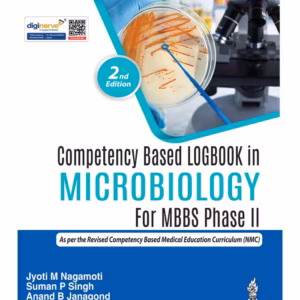

This edition laid out the management of critical emergencies such as STEMI, non-STEMI, and unstable angina. With the rapid growth of STEMI centers, the protocols and guidelines are very precise allowing emergency providers to save more lives. It includes the new classification guidelines of myocardial infarction with an explanation of the different types of MI. Additionally, stroke guidelines are clearer than ever before, and similarly have allowed improved patient outcomes. This book will increase the understanding of sepsis management and the rule of 1-1-1. It will help clinicians to simplify and manage complex emergencies.
101 Clinical Cases In Emergency Room
₹1,481.00
26% Off
Close
Price Summary
- ₹1,995.00
- ₹1,481.00
- 26%
- ₹1,481.00
- Overall you save ₹514.00 (26%) on this product
In Stock
Highlights:
- ISBN – 9789352703333
- Author – Badar M Zaheer
- Edition – 2nd Edition
- Publisher – Jaypee Brothers Publisher
- Year – 2020
- Binding – Paperback
- Language – English
Ask a Question
Ask a Question
42 People viewing this product right now!
Additional information
| Weight | 4.5 kg |
|---|---|
| Dimensions | 6.25 × 9.5 × 2 cm |
| Edition | 2nd Edition |
| Author | Badar M Zaheer |
| ISBN | 9789352703333 |
| Language | English |
| Year | 2020 |
| Binding | Paperback |
| Publisher | Jaypee Brothers Publisher |
| Pages | 416 |
Reviews (0)

There are no reviews yet.